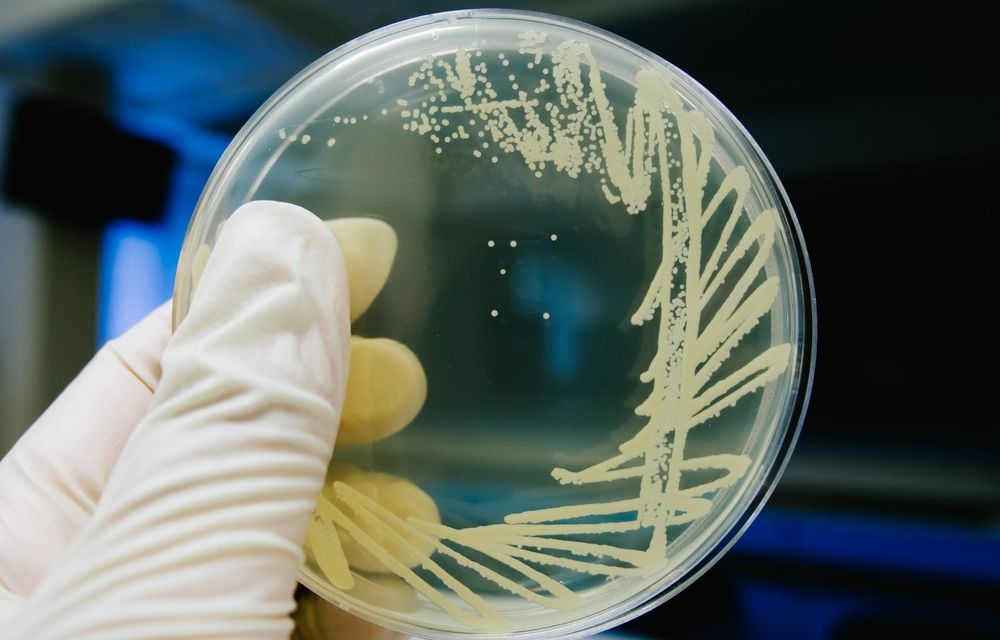

Terminas „genų inžinerija“ paprastai susilaukia daug komentarų ir nepriklausomai nuo to, ar jūs palaikote genetiškai modifikuotus maisto produktus, ar esate prieš juos, tačiau norite, kad produktų etiketės įvardintų, ką iš tiesų perkate. Gera žinia ta, kad GM pasaulis serviruoja kai ką naudingo ir susijusio su maistu.
Šiuo metu egzistuoja genetiškai modifikuota grybų rūšis, kurią galime aptikti duonoje ir kuri gal padėti išvalyti aplinką. O kaip žinome, aplinkai kaip niekad reikia pagalbos.
Septynių mokslininkų komanda Rumunijos ir Norvegijos institutuose sukūrė mieles, kurios gali padėt tvarkytis su tarša sunkiaisiais metalais. Pasak tyrimo, pačios efektyviausios dermės gali sugerti iki 80proc. metalų jonų.
Procesas, kurio metu augalai, mikrobai ar grybai šalina taršalus, vadinamas bioremediacija. Šis procesas yra pristatomas kaip geriausias būdas švarinti aplinką. Svarbu paminėti, kad aplinka yra užteršta sunkiaisiais metalais, situacija tampa kiek keblesnė, nes, pavyzdžiui, užterštame vandenyje augalai negali išaugti pakankamai aukšti, kad galėtų išvalyti taršalus.
Tarša sunkiaisiais metalais yra pavojinga tiek žmonėms, tiek gyvūnams, nes jie didina riziką sirgti vėžiu. Ši informacija skatina ieškoti sprendimo ir kuo greičiau, todėl mokslininkų komanda, kuriai vadovavo latvė Liliana Ruta iš Bucharešto universiteto, nusprendė žūtbūt rasti išeiti ir sukurti genetiškai modifikuotas mieles, kurios sugertų toksinus.
Mokslininkai sukūrė genus, panaudoję ląstelių membranų skeletus, žalius fluoresuojančius proteinus bei metalus sujungiančius peptidus. Mielės buvo sujungtos su skirtingų rūšių peptidais tam, kad būtų sugerti skirtingi sunkieji metalai. Cisteino peptidai, pavyzdžiui, geriausiai sugeria kadmį bei sidabrą, o tuo tarpu histamino peptidai sugeria nikelį bei kobaltą.
Šiuo metu aplinkai draugiškos mielės yra naudojamos tik laboratorijose, prireiks dar kelerių metų, kol jos bus naudojamos kaip valanti priemonė. Kitas žingsnis yra rasti būdą, kad genetiškai modifikuotos mielės galėtų tarnauti realiame gyvenime, pavyzdžiui vandens telkiniuose. Komanda taip pat susidūrė su dilema: kaip atsikratyti mielių, kai aplinka jau bus švari? Bet kokiu atveju, šis atradimas žada daug.

Skaityti komentarus